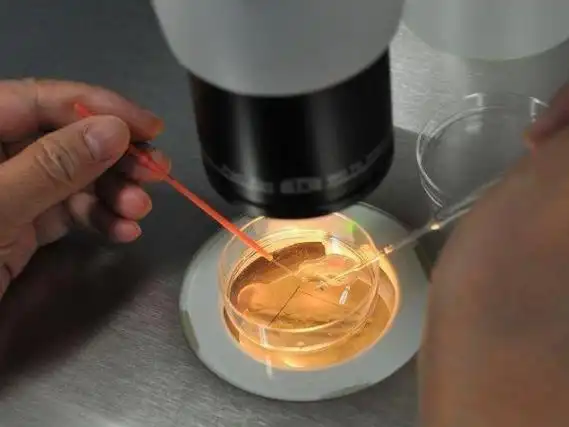

随着辅助生殖技术的不断发展,试管婴儿技术为许多不孕不育夫妇带来了生育的希望。然而,对于未婚女性来说,试管婴儿的政策限制是她们关注的焦点。那么,2026年没有结婚证去河南省妇产医院做试管婴儿是否可行呢?本文将为您详细解答,并提供试管流程及费用攻略。
2026年未婚女性在河南省妇产医院进行试管婴儿治疗的可行性:根据目前河南省的政策规定,未婚女性通常情况下无法在河南省妇产医院进行试管婴儿治疗。进行试管婴儿治疗需要提供结婚证、身份证等相关证件,以证明其符合国家计划生育政策和伦理规范。下面将详细介绍试管流程及费用,以便您更好地了解相关信息。
河南省妇产医院试管婴儿流程详解
在河南省妇产医院进行试管婴儿治疗,通常需要经过以下几个步骤:
1.术前检查
这是试管婴儿治疗的第一步,也是非常关键的一步。医生会对夫妻双方进行全面的身体检查,评估生育能力,确定是否符合试管婴儿的指征。检查项目包括:
女性检查:血常规、尿常规、肝肾功能、性激素六项、AMH(抗缪勒氏管激素)、B超检查(评估卵巢功能和子宫情况)、输卵管造影(了解输卵管是否通畅)、宫颈癌筛查等。
男性检查:精液分析、血常规、肝肾功能、性激素检查、染色体检查等。
费用预估:术前检查费用大约在3000-5000元左右,具体费用会因检查项目和医院收费标准而有所差异。
2.促排卵
促排卵的目的是为了获得多个成熟的卵子,提高试管婴儿的成功率。医生会根据女性的年龄、卵巢功能等情况,制定个性化的促排卵方案。常用的促排卵药物包括:
果纳芬
丽申宝
达必佳
在促排卵期间,需要定期进行B超检查和抽血化验,监测卵泡的发育情况,并根据情况调整药物剂量。
费用预估:促排卵药物费用差异较大,通常在5000-20000元之间。进口药物费用相对较高,国产药物费用相对较低。
3.取卵
当卵泡发育成熟后,医生会在B超引导下,通过阴道穿刺的方式取出卵子。取卵过程通常在麻醉下进行,患者不会感到明显的疼痛。
费用预估:取卵手术费用大约在3000-5000元左右。
4.体外受精与胚胎培养
取出的卵子会在实验室中与经过处理的精子进行体外受精。受精方式可以选择常规的体外受精(IVF)或者卵胞浆内单精子注射(ICSI)。受精卵会在培养箱中进行培养,发育成胚胎。
费用预估:体外受精与胚胎培养费用大约在10000-20000元左右。ICSI费用会略高于IVF。
5.胚胎移植
医生会选择优质的胚胎,将其移植到女性的子宫腔内。移植过程通常不需要麻醉,患者不会感到明显的疼痛。胚胎移植后,需要进行黄体支持,以提高胚胎着床率。
费用预估:胚胎移植费用大约在3000-5000元左右。黄体支持药物费用大约在1000-3000元左右。
6.妊娠确定
胚胎移植后14天左右,可以通过抽血化验HCG值来确定是否妊娠。如果妊娠成功,需要定期进行产检,确保胎儿的健康发育。
费用预估:妊娠检查费用根据检查项目而定,通常在数百元至数千元不等。
河南省妇产医院试管婴儿费用总览
在河南省妇产医院进行试管婴儿治疗,一个周期的总费用大约在3万-8万元左右。具体费用会因患者的年龄、身体状况、所选择的治疗方案以及药物种类而有所差异。此外,如果需要进行胚胎冷冻、解冻移植等操作,还会产生额外的费用。

注意事项
提前咨询:在进行试管婴儿治疗前,建议提前咨询河南省妇产医院的生殖医学专家,了解相关政策和流程,评估自身情况是否适合进行试管婴儿治疗。
做好心理准备:试管婴儿治疗是一个漫长而艰辛的过程,需要患者做好充分的心理准备,保持积极乐观的心态。
选择正规医院:选择正规、专业的医院进行试管婴儿治疗,可以提高成功率,降低风险。
遵医嘱:在治疗过程中,要严格遵医嘱,按时服药、复查,并注意休息和饮食。
*图文内容仅供学习参考,不能作为诊断依据,个体有差异,如有不适请前往正规医院就诊!

上海
重庆
北京
天津